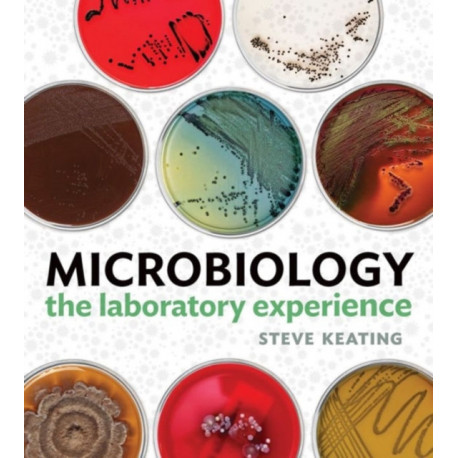

Kurv
Vare
varer
(tom)
Ingen varer
Fastlægges senere
Forsendelse
0,- kr
I alt
Microbiology: The Laboratory Experience
(Bog, Spiral bound, Engelsk)
Forlag:
WW Norton & Co
- Type: Bog
- Format: Spiral bound
-
Sprog:
Engelsk

- ISBN-13: 9780393923643
- Se flere detaljer ▼
Bemærk: Kan ikke leveres før jul.
Beskrivelse
Students get more out of their microbiology lab experience because the manual has thorough introductions that emphasize important concepts and applications---written in a uniquely-engaging authorial voice---and is accompanied by an unparalleled visual program.
Læsernes anmeldelser (0)
Alle detaljer
| Forlag | WW Norton & Co |
| Forfatter | Steven (Pennsylvania State University) Keating |
| Type | Bog |
| Format | Spiral bound |
| Sprog | Engelsk |
| Udgivelsesdato | 12-01-2016 |
| Første udgivelsesår | 2016 |
| Originalsprog | United States |
| Sideantal | 624 |
| Indbinding | Spiral bound |
| Forlag | WW Norton & Co |
| Sideoplysninger | 624 pages |
| Mål | 257 x 278 x 31 |
| ISBN-13 / EAN-13 | 9780393923643 |

